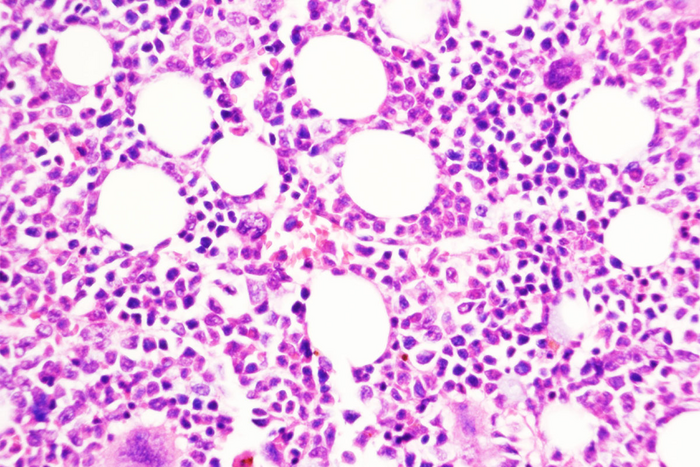
Study reveals how chronic blood cancer transitions to aggressive disease

Nature Cancer揭示了慢性血癌如何轉變為侵襲性疾病
圖片:圣路易斯華盛頓大學醫學院的一項研究提出了一種預防慢性、生長緩慢的血癌發展為侵襲性白血病的策略。圖中顯示的是用一種化合物阻斷DUSP6的小鼠骨髓,DUSP6是由慢性疾病轉變為侵襲性疾病的關鍵分子。
來源:Tim Kong, Angelo Laranjeira
一種慢性白血病可以潛伏多年。一些患者可能需要治療來控制這種類型的血癌——稱為骨髓增生性腫瘤(MPN),而另一些患者可能需要經過長時間的觀察等待。但對于一小部分患者來說,這種緩慢的疾病可能會轉變為一種侵略性的癌癥,稱為繼發性急性髓系白血病,這種癌癥幾乎沒有有效的治療方案。人們對這種轉變是如何發生的知之甚少。
但現在,圣路易斯華盛頓大學醫學院的研究人員已經確定了從慢性白血病向侵襲性白血病轉變的一個重要轉折點。他們已經證明,在具有該疾病模型的小鼠和具有取自人類患者的腫瘤樣本的小鼠中,阻斷過渡途徑中的一個關鍵分子可以防止這種危險的疾病進展。
這項研究發表在12月29日的《自然癌癥》雜志上。
“繼發性急性髓系白血病的預后很糟糕,”資深作者Stephen T. Oh博士說,“幾乎每一個有骨髓增生性腫瘤病史的急性白血病患者都會死于這種疾病。因此,我們研究的主要重點是更好地了解這種從慢性疾病到侵襲性疾病的轉變,并為這些患者開發更好的治療方法,并希望為這些患者提供預防策略。”
這項研究表明,抑制這種被稱為DUSP6的關鍵過渡分子有助于克服這些癌癥通常對JAK2抑制劑產生的耐藥性,JAK2抑制劑是通常用于治療它們的療法。JAK2抑制劑是一種抗炎療法,也用于治療類風濕性關節炎。
“這些患者通常使用JAK2抑制劑治療,但盡管采用了這種治療,他們的疾病仍在進展,所以我們也在試圖確定即使在JAK2抑制的情況下,疾病是如何惡化的”。
研究人員對這些腫瘤的遺傳學進行了深入研究,包括在緩慢的慢性階段和在患者服用JAK2抑制劑時疾病轉化為侵襲性形式之后。在本研究分析的40例腫瘤患者中,DUSP6基因高度表達。
使用遺傳技術刪除DUSP6基因可以防止這種癌癥模型小鼠向侵襲性疾病的轉變。研究人員還測試了一種抑制DUSP6的藥物化合物,并發現這種化合物(僅用于動物研究)在兩種不同的癌癥小鼠模型和從患者身上取樣的人類腫瘤小鼠中阻止了慢性疾病向侵襲性疾病的進展。在這些模型中,通過基因和藥物降低DUSP6水平也能減少炎癥。
由于抑制DUSP6的藥物無法用于人類臨床試驗,Oh和他的同事們對探索抑制DUSP6下游激活的另一種分子的治療方法很感興趣,他們發現這種分子也是延續DUSP6的負面影響所必需的。在臨床試驗中,有一些藥物可以抑制這種下游分子,即RSK1。Oh的團隊對研究這些藥物有興趣,因為它們有可能阻止從慢性疾病到侵襲性疾病的危險轉變,并解決對JAK2抑制的耐藥性。
Oh說:“未來的臨床試驗可能會招募正在服用JAK2抑制劑的骨髓增生性腫瘤患者,盡管如此,仍有證據表明他們的疾病惡化。”“到那時,我們可能會將目前正在試驗中的RSK抑制劑類型添加到他們的治療中,看看是否有助于阻止疾病發展為侵襲性繼發性急性髓系白血病。一種新開發的RKS抑制劑正在進行乳腺癌患者的一期臨床試驗,所以我們希望我們的工作為開發這種慢性血癌患者的新治療策略提供了一個有前景的基礎。”
文章標題
DUSP6 mediates resistance to JAK2 inhibition and drives leukemic progression

- 上一篇
一種新方法可以以前所未有的分辨率精確定位基因活性和蛋白質
一項由威爾康奈爾醫學院、紐約長老會醫院和紐約基因組中心的研究人員共同領導的研究表明,一種新方法可以以前所未有的分辨率闡明整個器官或腫瘤中細胞的身份和活動。1月2日發表在《自然生物技術》(Nature Biotechnology)雜志上的一篇論文描述了這種方法,它記錄了組織樣本中基因活動模式和細胞中關鍵蛋白質的存在,同時保留了細胞精確位置的信息。這使得創建復雜
- 下一篇

兩篇文章抓住腸子和大腦的新聯系
插圖描繪了人體的微生物構成。圖片來源:國家人類基因組研究所為了學會社交,斑馬魚需要相信自己的直覺(Gut)。俄勒岡大學對斑馬魚的新研究表明,腸道微生物會促使特定細胞修剪大腦回路中控制社會行為的額外連接。修剪對于正常社會行為的發展至關重要。研究人員還發現,斑馬魚和小鼠的這些“社會”神經元是相似的。這表明,這些發現可能會在不同物種之間轉化,并可能為
